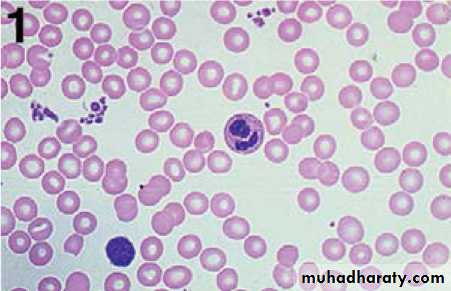

Anemia
Anemia
Definition. It is an abnormal decrease in the number of circulating RBCs, Hb conc., and hematocrit (PCV). It is not a disease itself but is a symptom of another disorder.It is important to consider the following developmental variations when evaluating an infant or child for anemia:
1-Hb level and PCV are relatively high in the newborn; these values subsequently decline, reaching a nadir at approximately 7 weeks of age for the premature infant and at 2 - 3 ms of age for the term infant. (This condition is referred to as the “physiologic anemia” of infancy or anemia of prematurity) .
Total Hb concentration and hematocrit rise gradually during childhood .
Normal values in children
2-Hb F is the major Hb of prenatal and early postnatal life.At cord blood ,Hb F values approached 70% then it decline postnatally; by 9 to 12 months of age, the Hb F values represent <2% of the total Hb concentration.
3-Mean corpuscular volume (MCV) is relatively high during the neonatal period but declines during the latter part of infancy.
The MCV is lowest during infancy, gradually increasing with age during childhood, reaching adult levels during adolescence.
Classification
In clinical practice, anemias are classified according to the morphologic appearance (i.e., color and size) of RBC on peripheral smear as
well as the MCV.
1-Hypochromic, microcytic (small, pale RBCs; a low MCV)
2-Macrocytic (large RBCs; a high MCV)
3-Normochromic, normocytic (cells of normal size and shape; a normal MCV)
Hypochromic, microcytic anemias
Defect. Hypochromic, microcytic RBCs indicate impaired synthesis of the heme or globin components of Hb.Defective heme synthesis may be the result of iron deficiency, lead poisoning, chronic inflammatory disease, pyridoxine deficiency, sideroblastic anemia, or copper deficiency.
Defective globin synthesis is characteristic of the thalassemia syndromes.
Evaluation. Laboratory studies that are useful in evaluating the hypochromic, microcytic anemia
1- Serum ferritin
2-Total s. iron-binding capacity.
3- Soluble transferrin receptor (sTR).
4- Quantitative measurements of the Hb A1 , Hb A2 and Hb F levels.
Normal
Hypochromic microcyticIron deficiency anemia
IDAThe commonest cause of iron deficiency in children is:
1- Inappropriate diet.2- Blood loss is uncommon.
Iron deficiency occurs from 6 months of age onwards when the child’s total body mass is expanding in the face of an inadequate iron intake
causes
1-Nutritional iron deficiency usually develops when rapid growth puts excessive demands on iron stores. This is seen mainly during:A-Infancy, when iron stores at birth are inadequate due to LBW or when the diet is composed exclusively of milk or cereals with low iron content
B-Adolescence, when a rapid growth spurt often coincides with a diet of suboptimal iron content (this is a particular problem in girls, who also lose iron with menses)
2-Iron deficiency resulting from blood loss.
A-Prenatal iron loss can result from extrusion of fetal blood either into the maternal circulation (fetomaternal transfusion) or into the circulationof a twin (twin-to-twin transfusion).
B-Perinatal bleeding may result from obstetric complications such as placental abruption or placenta previa.
C-Postnatal blood loss may be of an obvious cause (e.g., after surgery or due to trauma) or may be occult, as occurs in idiopathic pulmonary hemosiderosis, parasitic infestations, polyps, or inflammatory bowel disease.
Clinical features.
ID is most commonly seen between 6 and 24 months of age. The typical patient is on a diet consisting almost exclusively of milk.Symptoms. Although mild iron deficiency is relatively asymptomatic, as it becomes more severe, the infant manifests
1-irritability
2-anorexia
3-lethargy
4-pica (eating non-food stuffs)
5-apathy
6-easy fatigability.
Signs. On physical examination, the milk-fed infant is
1-fat2-pale
3-other findings include tachycardia and a systolic murmur. If the anemia is very severe, there may be signs of congestive heart failure .
4-other signs (such as koilonychia or angular cheilitis) are very rare.
ID causes serial changes in the blood before anemia develops.
Serum ferritin is reduced and eventually a microcytic, hypochromic anemia results. Usually the MCV (mean cell volume) and MCH (mean cell hemoglobin) fall before the Hb, but the changes can occur together. The MCHC (mean cell Hb concentration) is less useful .
stages of iron depletion
Diagnosis1-CBC: Anemia may vary from very mild to very severe, depending on the degree and duration of ID.
Small, pale RBCs are evident on the peripheral smear; the reduction in MCV, MCH and MCHC is usually proportional to the severity of the anemia.
2-The serum iron level is decreased, whereas the iron-binding capacity (transferrin level) is increased, and the percentage of saturation is low (usually <15%).
The serum ferritin level is decreased (which is a reflection of low iron stores in the bone marrow), and the sTR level is increased.
Differential diagnosis
1.Anemia of chronic disease or ‘anemia of inflammation’ (modification of iron regulation by the inflammatory response).2.Thalassemia traits , these require quantitation of Hb A2 and F, and not simply Hb electrophoresis. 3.Sideroblastic anemias .4-Lead poisoning.
Iron deficiency and neuropsychological effects
ID early in life will affects brain iron content and distribution, leading to neurotransmitter & behavioral alterations. IDA is significantly associated with poorer scores in developmental testing when compared with controls, particularly in coordination and spatial orientation skills.Therapy
IDA can be managed by administration of iron.
This can be provided by the oral route at a dosage of 6 mg/kg/day of elemental iron for a period of 2 to 3 months after the Hb level has returned to normal; this allows replenishment of tissue iron stores.
Dietary counseling must be simultaneously provided to caregivers to give the patient adequate amounts of dietary iron.
Dietary iron occurs in two forms , heme and nonheme.
Heme iron (in meat, fish and poultry) is well absorbed and its bioavailability is not affected by other dietary factors.Non-heme iron is less well absorbed and its bioavailability is affected by dietary factors because of the way it is bound in foods. It is present in beans, peanut butter, green leafy vegetables, dried fruit and fortified breakfast cereals.
Absorption of iron is enhanced by vitamin C and proteins, but is inhibited by a number of constituents of food and drink, for example tannins (in tea and legumes), phytates (in unrefined cereals), phosphates (in eggs), oxalates (in spinach) and polyphenols (in spinach, coffee).
Failure to respond to iron therapy, the commonest reason is due to failure of adherence.
Although many preparations may be prescribed three times a day, better adherence may be achieved with a single daily dose or twice daily dosing.Types of iron
1. Iron salts (e.g. sulphate, fumarate, gluconate and glycine sulphate).2. Polysaccharide iron complex. It has major advantages in pediatric practice . They do not stain the teeth and it can be mixed with milk or juice without altering absorption.
In general there are fewer GIT side-effects, and they are sugar-free. Perhaps most importantly, the child usually likes them.
Anemia of inflammation and chronic disease
The anemia of chronic disease is associated with a variety of disorders, including:
1-Chronic inflammatory disease (e.g., Crohn disease , juvenile inflammatory arthritis)
2-Chronic infection (e.g. T.B)3-Malignancy
4-A mild & transient form of anemia of inflammation may occur following infections, including common viral infections
Iron is not released from its storage sites in the macrophages; thus, it is unavailable for Hb synthesis in developing erythroblasts.
A modest decrease in the survival of RBCs and a relatively limited erythropoietin response to the anemia also contribute to the development of anemia.
Diagnosis
The anemia is mild in degree (i.e. Hb is 7–10 g/dL) often with hypochromic,microcytic indices.As in IDA, the serum iron level is reduced. However, in contrast with IDA, the iron-binding capacity is normal or reduced, and the serum ferritin( which is acute-phase reactant) level is increased or normal.
Therapy
The anemia resolves when the underlying disease process is treated adequately.Therapy with medicinal iron is unnecessary unless concomitant iron deficiency is present.